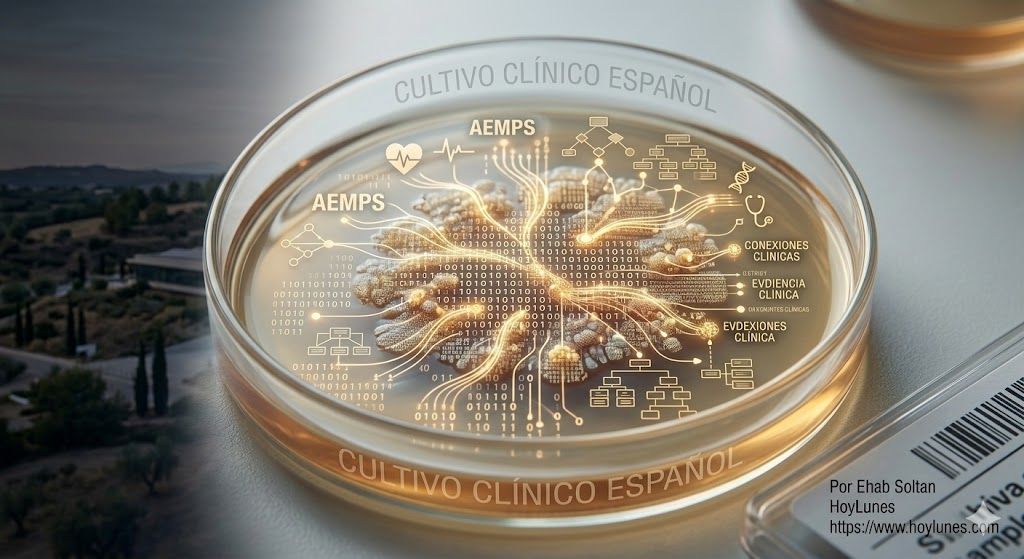

Cómo España se convirtió en el laboratorio preferido de las multinacionales — y por qué ese liderazgo aún no se traduce en poder industrial
Por Ehab Soltan
HoyLunes – Europa atraviesa una redefinición silenciosa de su ecosistema farmacéutico. La reforma regulatoria impulsada por la Comisión Europea, la aplicación progresiva del Reglamento europeo de Evaluación de Tecnologías Sanitarias (HTA) y la consolidación del papel científico de la European Medicines Agency están alterando el equilibrio entre investigación clínica, producción industrial y acceso a medicamentos. En este contexto, España ha logrado algo inesperado: convertirse en uno de los centros más dinámicos de investigación clínica de Europa sin haber consolidado aún una posición equivalente en producción farmacéutica o propiedad intelectual.
El fenómeno plantea una pregunta estratégica para el futuro del ecosistema biomédico europeo: ¿es España el nuevo hub clínico del continente o simplemente el campo de pruebas de la innovación farmacéutica global?

Anatomía de un liderazgo: el “milagro” regulatorio español
El liderazgo español en ensayos clínicos no surgió por casualidad. Fue el resultado de una convergencia regulatoria y organizativa poco común en Europa.
El punto de inflexión fue el Real Decreto 1090/2015, que modernizó el marco de investigación clínica en España y anticipó varios de los principios que posteriormente consolidaría el EU Clinical Trials Regulation.
El sistema introdujo tres cambios estructurales:
Centralización regulatoria en la Agencia Española de Medicamentos y Productos Sanitarios**, reduciendo la fragmentación administrativa.
Comités éticos coordinados, lo que permitió acelerar la aprobación de estudios multicéntricos.
Procedimientos armonizados con estándares europeos.
El resultado fue una reducción significativa en los tiempos de autorización de estudios clínicos y una mayor previsibilidad regulatoria para la industria. Según datos oficiales de la Agencia Española de Medicamentos y Productos Sanitarios, España se ha situado de forma recurrente entre los países europeos con mayor número de ensayos clínicos autorizados, con especial protagonismo en oncología, enfermedades raras y terapias avanzadas.
La consolidación de este modelo coincidió posteriormente con la entrada en vigor del Reglamento Europeo de Ensayos Clínicos, que creó un sistema armonizado para toda la Unión Europea mediante el portal Clinical Trials Information System (CTIS). La adaptación española resultó relativamente fluida precisamente porque gran parte de la arquitectura administrativa ya había sido anticipada por el marco regulatorio nacional de 2015. Esta alineación temprana explica por qué numerosos patrocinadores internacionales consideran hoy a España uno de los entornos regulatorios más predecibles para el lanzamiento de ensayos multicéntricos dentro de la Unión Europea.
La infraestructura invisible: la ventaja hospitalaria del SNS
Pero la regulación no explica todo. El verdadero activo estratégico español es su infraestructura sanitaria pública.
El Sistema Nacional de Salud (SNS) proporciona una red hospitalaria altamente capilar que permite reclutar pacientes con rapidez, coordinar ensayos multicéntricos e integrar investigación clínica en la práctica hospitalaria. Este modelo contrasta con sistemas sanitarios más fragmentados, donde la coordinación entre hospitales y centros de investigación resulta más compleja.
La consecuencia es un ecosistema particularmente atractivo para la industria farmacéutica: datos clínicos de alta calidad generados en entornos asistenciales reales.
Esta ventaja competitiva se enfrenta ahora a su prueba de fuego con el Espacio Europeo de Datos de Salud (EHDS). Si España lidera la digitalización de sus historias clínicas bajo este estándar, los datos generados en el SNS no solo servirán para ensayos, sino que podrían convertirse en el combustible de algoritmos de inteligencia artificial para el descubrimiento de fármacos, elevando el valor estratégico del activo clínico español.
El triángulo de poder europeo: España frente a Alemania y Francia
El liderazgo clínico español debe analizarse en relación con los otros dos grandes polos farmacéuticos de la Unión Europea: Alemania y Francia.
| Criterio | España | Alemania | Francia |
|---|---|---|---|
| Velocidad de reclutamiento | Alta | Media | Baja |
| Atractivo fiscal | Alto | Moderado | Alto |
| Foco industrial | Ensayos clínicos | Producción química y farmacéutica | Biotecnología |
Alemania sigue siendo el gigante industrial del sector farmacéutico europeo. Sin embargo, su estructura federal y las interpretaciones regionales del Reglamento General de Protección de Datos (GDPR) pueden ralentizar algunos procesos de investigación clínica.
Francia, por su parte, ha orientado su política industrial hacia biotecnología y terapias avanzadas, apoyándose en incentivos fiscales como el Crédit d’Impôt Recherche.
España ocupa una posición distinta: no lidera la producción, pero sí la generación de **evidencia clínica**. Este equilibrio crea una paradoja estratégica: Alemania tiene la industria; España, los datos.
Oportunidades y riesgos para las multinacionales
El atractivo clínico de España se desarrolla dentro de un ecosistema farmacéutico que ya posee un peso económico significativo. Según datos de Farmaindustria, la inversión anual en I+D farmacéutica en España supera varios miles de millones de euros y sitúa al sector entre los principales inversores privados en investigación del país.
Sin embargo, gran parte de esa inversión se concentra en investigación clínica y desarrollo de estudios internacionales patrocinados por multinacionales. El desafío estratégico consiste en transformar esa capacidad investigadora en mayor presencia de centros de decisión, plataformas biotecnológicas y producción industrial avanzada.
La nueva arquitectura regulatoria europea podría reforzar aún más el papel de España en la investigación clínica. La reforma farmacéutica impulsada por la Comisión Europea plantea incentivos regulatorios para las compañías que lancen nuevos medicamentos de forma simultánea en múltiples mercados europeos.
Para las multinacionales, esto implica diseñar estrategias de generación de evidencia que puedan sostener evaluaciones clínicas conjuntas bajo el Reglamento europeo de HTA.
En ese contexto, la capacidad de reclutar pacientes rápidamente y generar datos clínicos robustos convierte a España en un socio estratégico dentro de la red europea de investigación. La situación es especialmente relevante para áreas como inmunoterapia oncológica, vacunas de nueva generación, terapias avanzadas (ATMP) y terapias celulares como la CAR-T cell therapy, donde varios centros hospitalarios españoles han participado en programas pioneros europeos dentro del marco regulatorio de la European Medicines Agency.
El creciente papel científico de la European Medicines Agency también está redefiniendo el valor estratégico de los ecosistemas clínicos nacionales. En los últimos años, la agencia ha ampliado su actividad en áreas como terapias avanzadas, evaluación científica temprana y asesoramiento regulatorio para plataformas biotecnológicas emergentes. En este contexto, los países capaces de generar evidencia clínica robusta —especialmente en oncología, enfermedades raras y terapias génicas— adquieren un peso creciente en la arquitectura regulatoria europea.
El riesgo estructural: convertirse en “planta de ensayo”
Sin embargo, el ecosistema español padece una esquizofrenia administrativa: mientras la AEMPS acelera los ensayos, el sistema de precios y reembolso impone una de las esperas más largas de la Unión Europea para el acceso al mercado.
Esta brecha plantea una pregunta incómoda: ¿cuánto tiempo seguirán las multinacionales invirtiendo en I+D en un país que tarda cerca de dos años en incorporar esas mismas innovaciones a su cartera pública?
El liderazgo clínico, además, no garantiza liderazgo industrial. Existe un riesgo estratégico claro: que España se consolide como centro de ensayos clínicos sin capturar una parte proporcional de la cadena de valor farmacéutica.
Los ensayos generan conocimiento científico. Pero la fabricación y la propiedad intelectual generan capacidad industrial, inversión sostenida y autonomía estratégica.
La Unión Europea ha comenzado a abordar este desafío mediante iniciativas de política industrial sanitaria, como el PERTE para la Salud de Vanguardia, orientado a fortalecer la capacidad de producción biomédica y terapias avanzadas. La cuestión clave es si ese impulso político será suficiente para transformar el liderazgo clínico español en capacidad industrial.

La tesis estratégica: datos clínicos como poder geopolítico
La innovación farmacéutica se está convirtiendo en un activo geopolítico.
Estados Unidos domina la propiedad intelectual biotecnológica.
China acelera su capacidad de fabricación.
Europa intenta construir un modelo basado en regulación, ciencia y acceso equitativo.
En ese equilibrio, el liderazgo español en investigación clínica podría adquirir una importancia mayor de lo que hoy parece. Los datos clínicos no son solo evidencia científica; son infraestructura estratégica.
Si España logra convertir su ventaja en ensayos clínicos en una palanca para atraer fabricación, desarrollo tecnológico y centros de decisión, podría consolidarse como uno de los nodos más influyentes de la arquitectura farmacéutica europea.
Si no lo consigue, el país corre el riesgo de convertirse en algo más modesto: un eficiente laboratorio para innovaciones concebidas y producidas en otros lugares.
La pregunta ya no es si España puede liderar la investigación clínica europea. Esa posición parece consolidada. La verdadera cuestión es si el país será capaz de utilizar ese capital científico para atraer centros de decisión corporativos, inversión industrial y propiedad intelectual.
En el nuevo mapa farmacéutico europeo, los datos clínicos se están convirtiendo en una moneda de poder. La próxima década determinará si España decide utilizarlos como palanca estratégica o si acepta seguir siendo simplemente uno de los laboratorios más eficientes de Europa.
Fuentes
Comisión Europea – Pharmaceutical Strategy for Europe. [https://health.ec.europa.eu]
European Medicines Agency [https://www.ema.europa.eu]
Agencia Española de Medicamentos y Productos Sanitarios [https://www.aemps.gob.es]
OECD – Health at a Glance [https://www.oecd.org/health/health-at-a-glance/]
#InnovacionFarmaceutica #I+Dclinica #GeopoliticaSalud #AEMPS #MultinacionalesFarma #PoliticaIndustrial #HoyLunes #EhabSoltan
Este contenido es meramente informativo y no sustituye la consulta médica profesional.









